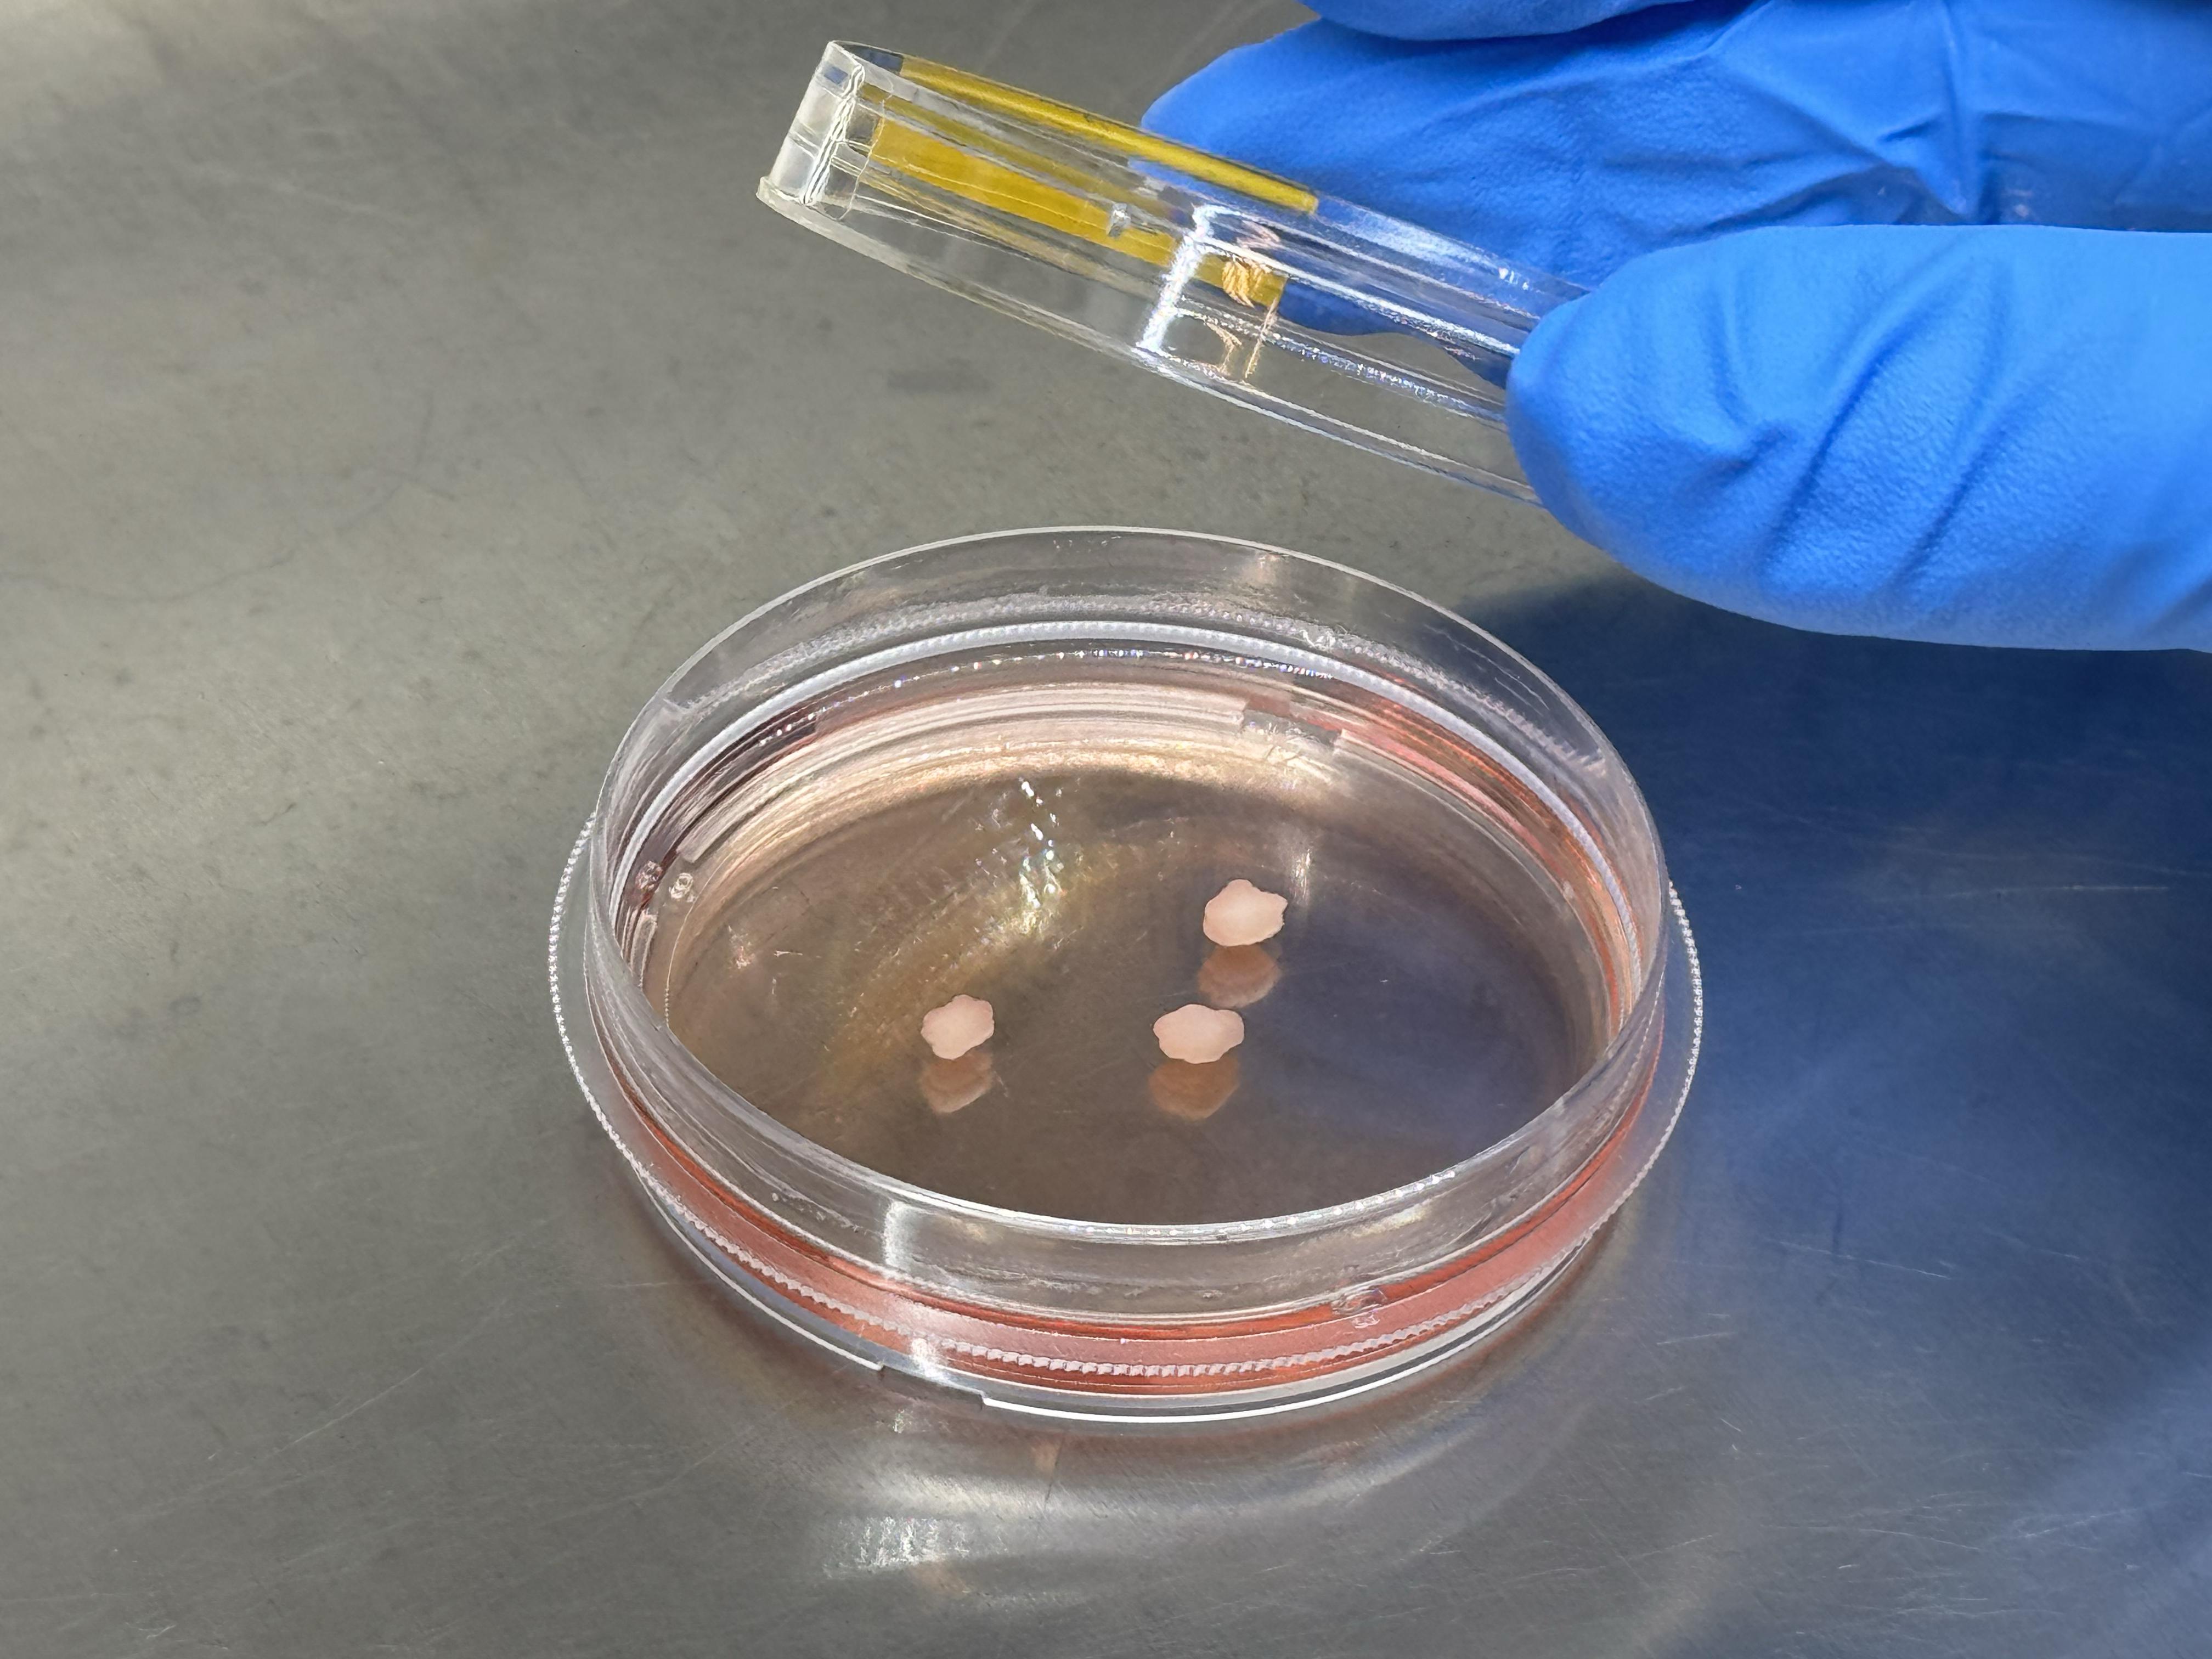

Les travaux pionniers de Fides Zenk, de l'animal aux organoïdes

Fides Zenk - 2025 EPFL - CC-BY-SA 4.0
A l’origine d’un travail très remarqué sur la transmission des marqueurs épigénétiques d’une génération à l’autre, la professeure en Sciences de la vie à l’EPFL développe des organoïdes de cerveau pour étudier le développement neurologique de l’embryon humain. Ses recherches ont été couronnées du Premier prix 3R pour son approche prometteuse.
Quel point commun peuvent bien avoir le gland d’un chêne, le cerveau d’un embryon de mouche, et un organoïde cultivé en laboratoire ? Aucun, si ce n’est qu’ils sont constitués de cellules. Pour en trouver un, il faut s’intéresser à la carrière passionnante de Fides Zenk, professeure depuis deux ans à la Faculté des Sciences de la vie de l’EPFL. Originaire de Basse-Saxe, au nord de l’Allemagne, c’est dès son plus jeune âge qu’elle a commencé à observer l’évolution et la métamorphose des plantes de la campagne environnante. « J’ai toujours aimé regarder ces processus biologiques. Voir comment ils évoluaient au fil des ans, l’apparition des fleurs et des fruits, puis le recommencement... Je pensais devenir écologiste, collecter différentes graines et plantes, et les cataloguer ! À l'université, j'ai appris la science sous-jacente et les mécanismes moléculaires. »
En étudiant les techniques de séquençage du génome dans son Master en biologie, Fides Zenk commence à s’intéresser à la régulation des gènes, processus essentiel à la différentiation cellulaire. De l’évolution de la graine à celle d’un embryon animal, il n’y a qu’un pas à franchir. « Chez l’animal, les schémas de régulation des gènes sont très intéressants. Au début de l'embryogenèse, on étudie une cellule qui ne transcrit pas encore : lorsque l'embryon se développe, il dépend uniquement de l'ARN et des protéines fournis par la mère, et le génome est complètement silencieux. La structure 3D du génome est alors établie, et tous les différents schémas de régulation se mettent en place avant que l'embryon ne commence à transcrire quoi que ce soit. C’est passionnant », se rappelle la scientifique.
Des travaux remarqués
Pour toute jeune chercheuse en génétique moléculaire du 21e siècle, difficile de s’intéresser à la régulation des gènes sans aborder l’épigénétique (voir encadré ci-dessous). Pour Fides Zenk, le champ des possibles de cette jeune discipline, dont l’essor est spectaculaire depuis 20 ans, est exaltant. Lors de son doctorat à l’Institut Max Planck d'immunobiologie et d'épigénétique de Fribourg, en Allemagne, c’est sous le prisme de l’épigénétique qu’elle étudie comment la vie émerge et évolue chez les êtres vivants. « J'y ai étudié la genèse des embryons de drosophiles et essayé de comprendre ce qui contrôle ces premiers moments de la vie. »
Je ne voulais plus travailler avec un modèle animal parce qu'on ne sait jamais ce qui peut être transposé à la santé humaine
La scientifique s’attache alors à la théorie, encore balbutiante, de la transmission de la mémoire épigénétique d’une génération à l’autre. Très remarqué, le travail de Fides Zenk à Fribourg permet de prouver que les instructions épigénétiques transmises par les mères aux embryons de drosophiles contribuent à réguler l'expression de leurs gènes. Une nouvelle de taille, démontrée peu après par une autre équipe sur les embryons de souris, suggérant un mécanisme conservé entre les espèces : l’embryon n’hérite pas seulement de l’information génétique de ses géniteurs, mais aussi d’une information réglementaire transmise par la mère à travers la machine épigénétique.
Le modèle des organoïdes
« À la fin de ma thèse, j'ai pensé que certains mécanismes qui contrôlent l'expression génétique très tôt dans l'embryon pourraient également être importants dans les cellules somatiques, au moment où les cellules se différencient. Mais je ne voulais plus travailler avec un modèle animal parce qu'on ne sait jamais ce qui peut être transposé à la santé humaine », explique Fides Zenk. C’est là qu’intervient un autre modèle d’étude, lui aussi nouveau et prometteur : les organoïdes, ces tissus en trois dimensions cultivés in vitro à partir de cellules souches humaines, dont les potentiels d’application en biologie et en médecine humaine sont importants.
Pour son post-doctorat au Département de science et d'ingénierie des biosystèmes de l’ETHZ à Bâle, Fides Zenk développe « des technologies permettant d'étudier l'épigénome à l’échelle d’une seule cellule cérébrale. Cela m’a permis de réaliser un atlas du développement précoce du cerveau à l'aide d'organoïdes de cerveau humain, pour comprendre comment les différentes modifications épigénétiques s'établissent et comment elles contrôlent les décisions relatives à la différenciation des cellules. »
Focus sur le développement embryonnaire du cerveau
C’est à présent au bord du lac Léman, qu’elle va poursuivre sa passion pour l’émergence de la vie et développer ses technologies dans les laboratoires du Campus Biotech de l’EPFL, à Genève. « Nous nous orientons vers une recherche plus appliquée à l’humain, afin de comprendre les troubles précoces du développement et, en particulier, les troubles du développement neurologique qui sont probablement établis très tôt dans le développement embryonnaire humain ». Avec, à la clé peut être, le développement de thérapies. Un travail, ici encore, remarqué : Fides Zenk a obtenu cet été le premier prix 3R du Centre de compétence suisse 3RCC, qui distingue une contribution majeure au principe des 3R (Remplacer, Réduire, Raffiner) dans l’expérimentation animale. « Traditionnellement, les études sur la formation précoce du cerveau s'appuient largement sur des modèles animaux, en particulier des souris, qui ne parviennent souvent pas à reproduire la biologie spécifique à l'humain. Les travaux de Fides Zenk remettent en question cette norme », argumente le 3RCC.
Tant à Genève qu’au campus lausannois de l’EPFL, où elle dispose d’un laboratoire et dispense des cours de Bachelor, c’est dans un riche environnement où se côtoient biologistes et ingénieurs que Fides Zenk entend désormais créer un système d’étude fiable, utile à la communauté neuroscientifique pour répondre à l’immense étendue de questions relatives au développement du cerveau. Et aussi, tant qu’à faire, apprendre le français, pour pouvoir encore mieux échanger avec ses étudiantes et étudiants et leur transmettre son savoir épigénétique.